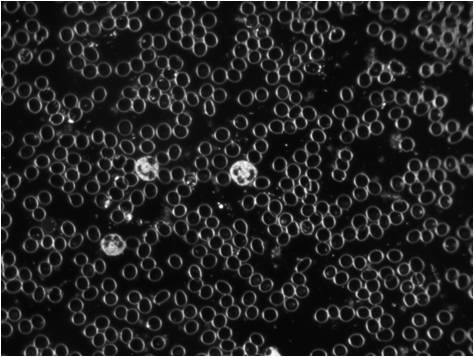

Microscopia de Campo Escuro
Microscopia de Campo Escuro
Técnica que utiliza uma gota de sangue vivo. É feita através de uma colheita num dedo do paciente e é observado ao Microscópio.
No Microscópio de Campo Escuro, o sangue permanece vivo e activo. Desta forma, é possível observar a movimentação dos componentes celulares, tal como acontece no organismo. É um método visual, já que a imagem do Microscópio é replicada num ecrã, o que permite que tanto o paciente como o terapeuta vejam o sangue na sua forma nativa. É uma confirmação dos processos dinâmicos que acontecem no organismo e permite ver o impacto das escolhas que se fazem, nomeadamente nutrição e estilo de vida, na vitalidade dos fluidos corporais. O exame não deve durar mais de 20 minutos, já que após esse tempo há degradação das características do sangue.
O exame permite uma avaliação directa da qualidade do sangue, permitindo conhecer o estado da saúde e de que forma progridem as doenças. Contudo, por si só, a triagem de sangue vivo com microscopia não é um procedimento de diagnóstico. Os resultados obtidos têm uma subjectividade associada ao observador não sendo quantificáveis, mas sim qualificáveis.
As observações morfológicas são feitas nas variações de tamanho, forma, proporções e estrutura dos eritrócitos, glóbulos brancos, plaquetas e outras estruturas plasmáticas.
As observações podem inferir:
Risco Cardiovascular: Grau de agregação eritrocitária, presença de fibrina, grau de agregação plaquetárias, oxidação/carga de radicais livres (ambiente ácido ou alcalino).
Actividade Imunológica: Viabilidade dos neutrófilos, capacidade fagocitária, proporções qualitativas entre os diferentes tipos de glóbulos brancos.
Capacidade de Absorção de Vitaminas e Minerais: Deficiência Nutricional determinada pela forma e tamanho dos eritrócitos (deficiência de ferro, ácido fólico, ácidos gordos e outros).
Saúde Digestiva: Existência de permeabilidade intestinal, capacidade digestiva (muitas vezes há acumulação de gorduras e proteínas não digeridas visíveis), microbiologia e disbiose (supercrescimento de bactérias intestinais, presença de fungos ou possíveis parasitas).
Stress Hepático: Capacidade detox do fígado, presença de cristais de colesterol ou ácido úrico, presença de metais pesados e acumulação de toxinas do meio ambiente (placas aterogénicas).
No exame microscópico de células vivas sanguíneas e outros elementos do sangue, os desvios observados na morfologia “normal” (forma, tamanho, cor, actividade, etc…) são interpretados de acordo com o que se conhece acerca destas mudanças morfológicas e como se correlacionam com o organismo (carga de toxinas, produtos químicos, microorganismos, funções fisiológicas e fisiopatológicas, etc…) e tensões corporais (tanto físicas como emocionais).
Após a observação, o terapeuta fará as recomendações necessárias para corrigir os desequilíbrios verificados. Poderá ser desde a recomendação de suplementação alimentar, alterações do estilo de vida ou encaminhamento para uma consulta médica ou acompanhamento nutricional.
Quer falar conosco
Por favor, entre em contacto
933 120 592
Horário de funcionamento
-
Segunda feira - Sexta feira
10h00 - 20h00
-
Sábado
10h00 - 13h00
-
Domingo
(Fechado)
Marque uma consulta
Poderá solicitar a sua marcação ao preencher os seus dados em baixo.
“É necessário muito pouco para provocar um sorriso e basta um sorriso para que tudo se torne possível.”
Gilbert Gesbron
Economize consulte nossos planos parceiros
sobre serviços odontológicos e complementares.


